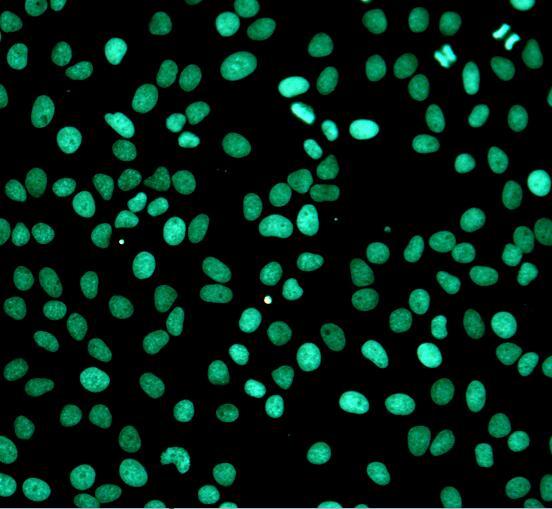

细胞状态检测专题|增殖及凋亡检测
一、不同的细胞状态
活细胞:细胞结构完整,代谢稳定,活力正常;
衰老细胞:细胞周期停滞;
毒性细胞:细胞增殖活力降低,代谢减慢;
凋亡细胞:细胞脂膜外翻,膜电位消失,DNA断裂片段化,为程序性死亡;
坏死细胞:丧失膜完整性,细胞膜逐渐溶解,释放内容物。
二、细胞增殖检测
细胞增殖的检测对于评估细胞健康,确定遗传毒性或评估抗癌药物至关重要,目前直接测量 DNA 合成是最准确的方法。EdU法相对于BrdU法无需使用抗体、操作便捷、检测灵敏度高,基于EdU掺入和后续的Click反应,叠氮化物和炔烃之间由铜催化的共价反应,整个反应 30 min 内可完成。
优势特点:
组分齐全:提供优化的阴性对照品,排除假阳性;
简单方便:无需抗体,无变性步骤,保持细胞形态和DNA完整性;
稳定可靠:独特的荧光染料具有良好的光稳定性与抗淬灭性。
实验结果展示

EdU法细胞增殖成像分析试剂盒(绿色荧光)检测Hela细胞结果

EdU法细胞增殖成像分析试剂盒(橙色荧光)检测Hela细胞结果
三、细胞凋亡检测
不同凋亡时期的标志特征
早期:细胞脂膜外翻,线粒体膜电位消失;
中期:大量Caspase活化;
晚期:DNA片段化,断裂的DNA暴露出游离3’-OH。
针对不同时期细胞凋亡的标志性特征,Abbkine提供相应的检测试剂盒,供广大用户随心选择。
优势特点:
提供优化的阳性对照品,解决凋亡检测非标准化的问题;
独家优化的实验方案,分别适用于荧光酶标仪、荧光显微镜、流式细胞仪;
通用的荧光检测参数,检测方便。
实验结果展示

一步法TUNEL细胞凋亡检测试剂盒(绿色荧光)(左)(红色荧光)(右)检测Hela细胞,10U/mL Dnase Ⅰ处理10 min。
Abbkine细胞状态系列产品让您的细胞状态检测实验更加便捷省心,免除您的后顾之忧!
产品推荐:
| 货号 | 名称 | 规格 | 价格(¥) |
| KTA4001 | 线粒体膜电位分析试剂盒(JC-1法) | 20T/100T/500T | 416/1216/3616 |
| KTA2030 | EdU法细胞增殖成像分析试剂盒(绿色荧光) | 100T/500T | 498/1198 |
| KTA2031 | EdU法细胞增殖成像分析试剂盒(橙色荧光) | 100T/500T | 498/1198 |
| BMU106-CN | SuperKine™ 超敏型细胞增殖检测试剂(CCK-8) | 200T/1000T/10000T | 98/298/2398 |
| KTA1020 | 细胞增殖/毒性检测试剂盒(CCK-8法) | 1000T/10000T | 498/2998 |
| KTA1001 | 活/死细胞双染色试剂盒 | 100T/500T/2000T | 498/898/1698 |
| KTA2010 | 一步法TUNEL细胞凋亡检测试剂盒(绿色荧光) | 50T /100 T | 1898/3198 |
| KTA2011 | 一步法TUNEL法细胞凋亡检测试剂盒(橙色荧光) | 50T /100 T | 1898/3198 |
| KTA0002 | Annexin V-AbFluor™ 488/PI双染细胞凋亡检测试剂盒 | 50T/100 T | 498/598 |
| KTA0001 | Annexin V-AbFluor™ 405 细胞凋亡检测试剂盒(蓝色荧光) | 50T/100 T | 1269/2116 |
| KTA0003 | Annexin V-AbFluor™ 555 细胞凋亡检测试剂盒(橙色荧光) | 50T/100 T | 1269/2116 |
| KTA0004 | Annexin V-AbFluor™ 647 细胞凋亡检测试剂盒(红色荧光) | 50T/100 T | 1269/2116 |
| KTA3020 | Caspase-1 活性分析试剂盒(比色法) | 20 T/50T/100 T | 739/1269/2316 |
| KTA3021 | Caspase-2 活性分析试剂盒(比色法) | 20 T/50T/100 T | 739/1269/2316 |
我们将持续更新更多技术前沿资讯,敬请期待!
Abbkine的技术专家为了给广大读者提供学习生物知识的平台,经过不懈努力,将多种高端生物实验的干货整理出来,后期陆续在微信公众号中刊登,请广大热爱科学的读者持续关注Abbkine公众号。

赋能细胞研究与治疗 Enabling cell research and therapy
亚科因生物技术有限公司(Abbkine Biotechnology Co., Ltd)成立于2017年,总部位于中国武汉。公司致力于细胞科研检测及细胞治疗领域关键试剂的研发、生产和销售,成为全球细胞制药领域创新的关键推动者。公司主营业务包括细胞培养、扩增及储存试剂,细胞代谢、检测及分选试剂盒,细胞治疗用原料及细胞因子等产品及定制化服务。围绕生物试剂研发,亚科因生物已建立了稳定完善的两大关键技术平台:生化试剂配方和重组蛋白表达进化平台,为细胞科研检测及细胞治疗核心试剂的高通量、高效率研发生产提供保障。

